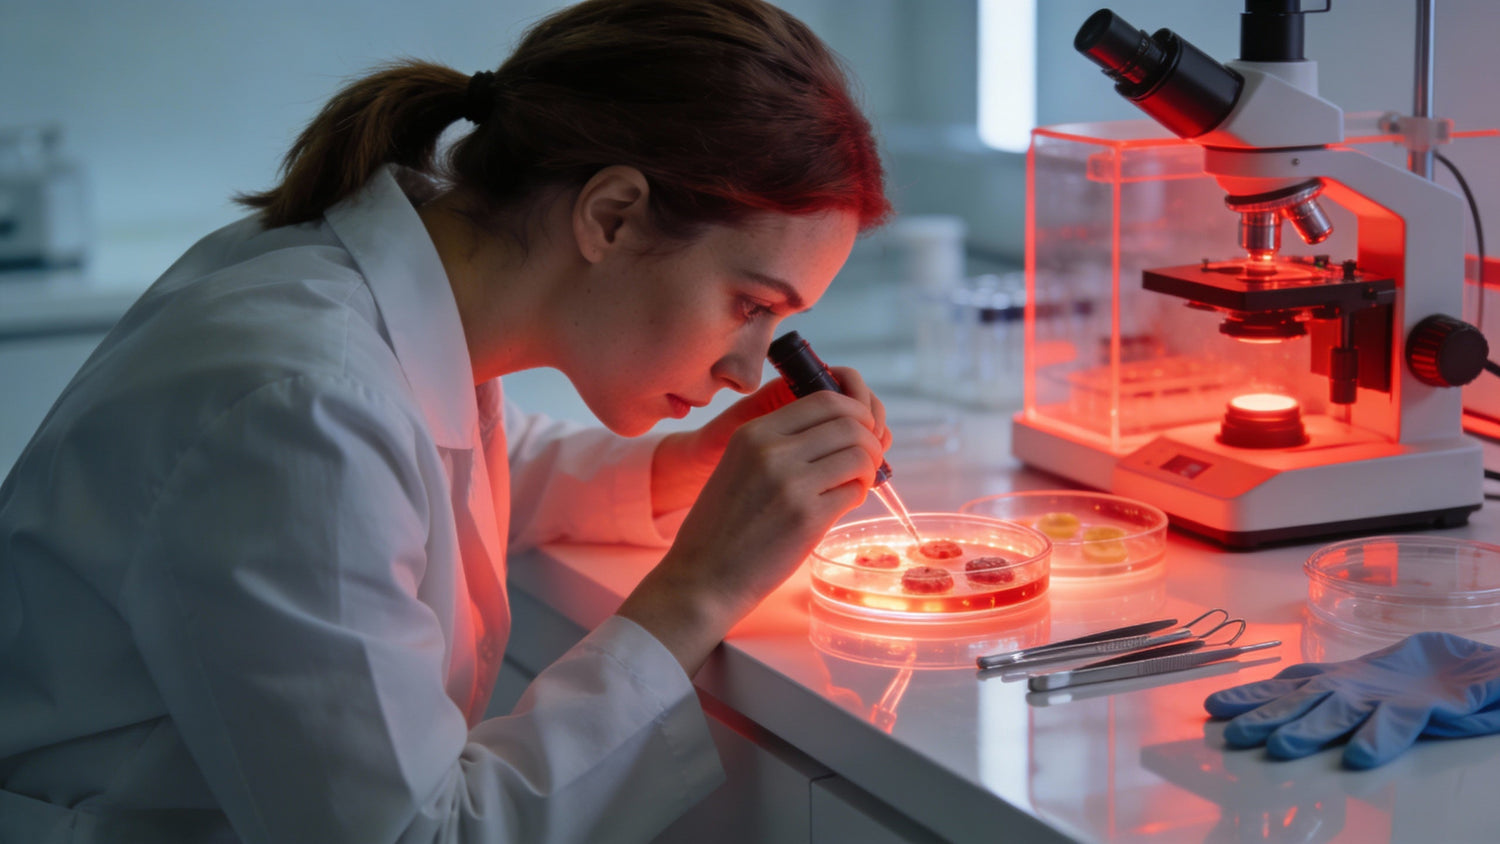
Why Fat Tissue Loves Near‑Infrared Light: A Deep Dive For Serious Light Therapy Users

Near‑Infrared 101: The Hidden Optical Window In Your Body
When you stand in front of a red or near‑infrared (NIR) panel, you are stepping into a very specific slice of the electromagnetic spectrum. In biology, that slice matters more than most people realize.
Biological tissue has what physicists call a near‑infrared “optical window,” roughly from about 650 to 1,350 nanometers. In this band, light can penetrate far deeper than in visible wavelengths. A major review in biomedical optics shows that outside this window, light gets swallowed quickly by strong absorption from blood at shorter wavelengths and water at longer wavelengths. Inside the window, scattering is the dominant interaction. Photons bounce off membranes, nuclei, mitochondria, and other microstructures, which sends them on long, zig‑zag paths.
Two things determine what happens to that light: the absorption coefficient, which is the probability that a photon will be absorbed per unit distance, and the scattering coefficient, which tells you how often the photon gets deflected. Even though water and hemoglobin are the big absorbers, fat and melanin also contribute, especially as you move deeper into the NIR region.
Because scattering is high and only weakly dependent on wavelength here, photons travel a much longer effective distance than the straight‑line depth would suggest. An engineering parameter called the effective attenuation coefficient combines absorption and scattering into a single number. It is this combined behavior that determines how far light can get into the body and how much energy gets deposited into each layer, including your subcutaneous fat.
In practical terms, NIR light in this window can travel on the order of a few inches through tissues under favorable conditions. Studies in breast and brain imaging have shown that microwatt‑level NIR sources can pass through roughly 4 in of breast tissue and around 1.5 to 3 in of muscle or neonatal skull–brain at higher powers. That is why NIR is used clinically for things like brain oxygenation monitoring, deep muscle spectroscopy, and fluorescence‑guided surgery. It is also why biohackers are understandably excited about the idea of reaching deeper fat depots.

What Makes Fat Tissue Optically Unique?
From an optical standpoint, your body is a cocktail of chromophores and structures: hemoglobin in blood, water in essentially every hydrated tissue, melanin in the epidermis, lipids in adipose tissue and membranes, and highly organized protein structures in muscle and bone. Each component has its own absorption spectrum and scattering profile.
A detailed analysis of the NIR window in biological tissue highlights that fat is one of the major components of tissue, often making up between about 10 and 40 percent of volume depending on the region. Although fat’s absorption spectrum has been less thoroughly mapped than that of hemoglobin or water, published spectra from pig fat demonstrate that fat does have its own absorption features within the NIR range. On top of that, adipose tissue is structurally distinct: it is packed with lipid‑filled cells, interspersed with connective tissue and relatively sparse microvasculature compared with muscle.
That structural difference shows up in two key optical behaviors.
First, fat has relatively lower blood content and somewhat different water content than muscle. Because hemoglobin is a strong absorber below about 700 nanometers, fat looks comparatively more transparent at those shorter red wavelengths. As you move into deeper NIR bands, water absorption ramps up, and both water and lipids develop overtone and combination bands related to CH, CH2, and OH vibrations. Spectroscopy work that probed human muscle and surrounding tissues found distinct minima in reflectance around 762, 973, 1,206, 1,442, 1,796, 1,930, and 2,186 nanometers, associated with bonds found in water, lipids, and proteins. Adipose tissue, rich in CH and CH2 groups, contributes strongly to some of these NIR bands.
Second, fat is a highly scattering medium. Scattering comes from refractive index mismatches across cell membranes, lipid droplets, and other microstructures. Core optical references in biomedical photonics identify cell nuclei and mitochondria as major scatterers, and adipocytes add their own internal refractive index boundaries. Scattering increases the photon path length within the fat layer, which raises the chance that those photons will be absorbed by lipids and water even if the raw absorption coefficient is modest.
A simple mental model helps. Imagine shining light through a clear glass of water versus a milky glass with fat droplets. In water, photons mostly go straight through or get absorbed quickly by specific molecules. In the milky mixture, photons bounce around far more before exiting, which increases the total distance they travel inside the medium. That extended residence time is exactly what happens when NIR light enters subcutaneous fat.
For NIR therapy, this means that fat is not simply a passive slab in front of deeper tissue. It is an active optical layer that can trap and re‑route photons, and, in some wavelength bands, absorb them quite efficiently.
How We Know NIR “Sees” Fat: Phantoms, Scanners, And Real Adipose Tissue
If fat were optically irrelevant, changes in subcutaneous fat thickness would not meaningfully affect NIR measurements. In reality, they are a major confounder in muscle spectroscopy and a major opportunity in fat‑focused imaging.
One influential Optics Express paper used a two‑layer Monte Carlo model and matching physical phantoms to study exactly this problem. The researchers built a system with a fat‑like top layer and a muscle‑like bottom layer and varied the fat thickness from 0 to about 0.47 in in steps of roughly 0.08 in. They fired ten to the eighth photons into this model and tracked how many came back to a detector 1.6 in away, focusing on a wavelength around 760 nanometers where deoxyhemoglobin absorbs strongly.
As the simulated fat layer got thicker, the normalized diffuse reflectance at the detector increased in a predictable way. When they built real phantoms, 5.9 in across with a 2.8 in thick muscle‑mimicking layer and variable fat‑mimicking caps, they saw the same pattern: thicker fat led to higher detected reflectance at 760 nanometers. This is not intuitive until you remember that fat and muscle have different optical properties. The fat layer, with its particular combination of absorption and scattering, sends more photons back toward the surface detector, and at the same time shields the deeper muscle layer from being sampled.
From a muscle‑oxygenation standpoint, this is a problem. Both a major Journal of Applied Physiology review on near‑infrared spectroscopy and a chapter on muscle NIRS point out that adipose tissue thickness systematically reduces sensitivity to muscle hemodynamics and distorts linearity in continuous‑wave NIRS measurements. Researchers are forced to measure skinfold thickness, estimate differential pathlength factors, and build corrections for adipose thickness into their models. When they do not, subjects with thicker fat layers appear to have different muscle oxygenation profiles even when their muscle physiology is the same.
From a fat‑centric perspective, that same phenomenon is telling you something important: NIR photons are spending more of their time in the fat layer as it gets thicker. That is exactly what you would expect if the tissue is interacting strongly with the light.
Another line of evidence comes from diffuse optical spectroscopic imaging (DOSI), a technology that was adapted at the University of California, Irvine to monitor subcutaneous fat during weight‑loss interventions. DOSI combines frequency‑domain photon migration with broadband NIRS to measure absorption and scattering across a wide spectral range. From those measurements, it derives concentrations of oxyhemoglobin, deoxyhemoglobin, total hemoglobin, water, and lipids, and then calculates a tissue optical index of fat metabolism.
In a pilot trial of ten overweight adults on a three‑month calorie‑restricted diet, DOSI detected near‑infrared changes in the optical properties of subcutaneous fat that matched existing hypotheses about how adipocytes respond to caloric restriction. The fact that DOSI works so well in fat is not a coincidence. Its developers explicitly note that it is “well‑suited to superficial, low‑absorbing tissues like subcutaneous fat,” which again reflects a balance of modest absorption, strong scattering, and favorable geometry.
Finally, there is a third, more cautionary tool: near‑infrared interactance for body composition. This method shines NIR light into the upper arm or other sites and uses the returning signal to estimate body fat percentage. Large validation work summarized by an anthropometry measurement toolkit confirms that near‑infrared interactance is highly repeatable but poorly valid against reference methods like underwater weighing across almost all populations, including children, adults, older adults, and people with obesity. The method’s very existence, though, underscores that NIR signals are strongly influenced by subcutaneous fat. The failure is not that NIR does not “see” fat; it is that body composition is more complex than a simple one‑site optical measurement can capture reliably.

From Light To Biology: How NIR Changes Fat Cells
Optical interaction is interesting. Biological response is what matters to a wellness optimizer. Here the story gets even more intriguing, and a little more nuanced.
Non‑thermal NIR Effects In Animal Fat And Bone
One of the most striking preclinical studies examined broadband NIR in the 1,100 to 1,800 nanometer range (with 1,400 to 1,500 nanometers filtered out). These wavelengths are strongly absorbed by water, hemoglobin, and myoglobin, so they couple energy into both soft tissue and bone. Researchers exposed the dorsal skin over the lumbar spine of male rats using a clinical NIR device that delivered 40 joules per square centimeter in each pass, two passes per session, on days 0, 7, and 14. The total dose was 240 joules per square centimeter, delivered through a cooled sapphire contact tip at about 68°F to keep the surface non‑thermal.
When they examined the animals up to six months later, several clear patterns emerged. Subcutaneous adipocytes above the thin muscle fascia were abruptly induced by NIR at seven days and remained significantly more numerous than in non‑irradiated controls at days 7, 30, 90, and 180. Bone marrow adipocytes also increased sharply at seven days and stayed elevated out to six months. Cortical bone thickened significantly at 90 and 180 days, while hematopoietic bone marrow cells dropped and never fully returned to control levels. CD34‑positive stem and progenitor cells increased and localized along the inner bone surface.
Crucially, there was no superficial necrosis, inflammation, or fibroblast overgrowth. The changes were predominantly apoptotic and remodeling in character, which is why the authors describe the effects as non‑thermal. They also calculated that the total NIR dose corresponded to about 8 hours and 45 minutes of sun exposure at sea level in North America, based on solar irradiance and the fraction of that energy in the 1,100 to 1,800 nanometer band.
This is not a “fat‑melting” story. It is a remodeling story. Non‑thermal NIR at high doses reorganized adipocytes and bone over months. For a home user or clinician, the take‑home is that deep NIR, when heavily absorbed by water and hemoglobin, is biologically active in fat and bone even without heat. That can be harnessed therapeutically, but it also demands respect in terms of dosing and long‑term safety.
Low‑Level Light Therapy And Human Fat: Shrinking Cells, Not Destroying Them
On the human side, most of the fat‑related work has focused on low‑level light therapy (LLLT) or photobiomodulation, using red and near‑infrared light in the 600 to roughly 950 nanometer range, at energy densities much lower than the animal study above.
A clinical review from the aesthetic and laser medicine space summarizes the key mechanism for fat loss like this: red and NIR light act on adipocytes to trigger the release of triglycerides, shrinking cell volume without killing the cells outright. The likely pathway involves mitochondrial stimulation, increased ATP, cyclic AMP signaling, and transient changes in membrane permeability. In other words, you are nudging the cells to dump their stored fuel into circulation, where it can be burned if the metabolic demand is there.
Several human trials support small but consistent body contour changes when light is combined with lifestyle.
In one case series from a laser clinic, women with localized abdominal fat received a combination of red laser at 630 nanometers, infrared laser at 808 nanometers, and blue LED at 450 nanometers. They completed twelve sessions, two per week. The treatment delivered about 1.5 joules per point each from red and infrared, plus 45 joules of blue, across quadrants of the abdomen. After the series, mean upper, middle, and lower abdominal circumferences dropped by roughly 4 to 5 centimeters each, with every participant showing some reduction and no reported adverse events.
Importantly, the authors emphasize that this is a small, uncontrolled pilot. It is promising but not definitive. The mechanistic rationale is interesting: red light is proposed to create transient pores in adipocyte membranes and support lipolysis, infrared reaches deeper fat layers, and blue light promotes nitric oxide release from hemoglobin, enhancing microcirculation and addressing cellulite‑related vascular issues.
Larger, more controlled work supports similar themes. A trial reported in Lasers in Surgery and Medicine followed 64 obese women over 20 weeks. All participants did structured exercise three times per week, but only some received post‑exercise red and near‑infrared light therapy. Those who combined exercise with light lost more fat mass, gained more skeletal muscle mass, and showed higher adiponectin, a hormone linked with healthier fat tissue. Another study with 55 participants used red and NIR LED therapy plus 30 minutes of aerobic exercise three times per week for four weeks and found significant, safe abdominal fat reduction without reported side effects.
A broader evidence‑based guide on red light therapy for fat loss, produced for strength and conditioning professionals, notes that photobiomodulation in the red and near‑infrared bands can penetrate adipocytes, promote triglyceride release, activate mitochondrial enzymes like cytochrome c oxidase, and may induce controlled adipocyte apoptosis in obesity. Small human studies suggest that when this light is layered onto an exercise and nutrition program, it can nearly double fat loss in some individuals compared with the same program without light. However, the guide also stresses that data are still limited, protocols vary, and more randomized trials are needed.
NIR, Metabolism, And Appetite Hormones
Fat loss is more than geometry. It is hormones, appetite, and systemic inflammation. Here NIR seems to have some interesting side benefits.
A controlled trial in the International Journal of Endocrinology on people with poor sleep found that red light exposure improved leptin levels and reduced ghrelin, the classic satiety and hunger hormones. That hormonal shift could make it easier to sustain a calorie‑restricted diet. Other work in post‑surgical and chronic‑pain contexts has documented that red and NIR therapy lowers inflammatory cytokines and pain, which indirectly supports movement and adherence to exercise.
When you stack these pieces together, you start to see why fat tissue “likes” near‑infrared light in a functional sense. The photons not only interact strongly with the adipose layer; they also trigger signaling that changes adipocyte behavior, surrounding vasculature, and systemic regulators of metabolism.
Practical Guidance: Using Light To Target Fat Without Fooling Yourself
The geeky optics are fun, but the question every serious home user eventually asks is simple: knowing that fat interacts strongly with NIR, how do I design a smart protocol?
Choosing Wavelengths And Devices
Most fat‑focused human work sits in two wavelength camps.
The first is red and near‑infrared photobiomodulation around 630 to 660 nanometers and roughly 780 to 950 nanometers. This includes many LED panels and low‑level lasers. Mechanistically, these bands line up with mitochondrial chromophores in adipocytes and adipose‑derived stem cells. A laboratory study in human adipose‑derived stem cells showed that red light at 660 nanometers and NIR at 810 nanometers both stimulate proliferation, while shorter blue and green wavelengths inhibit it. That fits the broader story of red/NIR supporting energy production and controlled growth, with blue/green driving more stress and differentiation.
The second camp is deeper infrared, including water‑filtered infrared used in endurance‑exercise studies and the 1,100 to 1,800 nanometer window used in the rat bone and adipocyte study. In one clinical trial cited by an infrared training studio, water‑filtered infrared irradiation during moderate cycling exercise, combined with appropriate nutrition, improved body composition, local fat distribution, and overall body weight in obese individuals. These wavelengths couple more strongly to water, so they deliver energy differently: more as gentle volumetric heating and less through classic photobiomodulation of cytochrome c oxidase.
From a practical standpoint, a large LED panel emitting around 660 and 810 nanometers is a reasonable starting point if your goal is to support fat loss while also improving skin and muscle recovery. Infrared saunas and water‑filtered infrared devices lean more toward circulatory, detoxification, and comfort effects, and they can be excellent adjuncts, especially if they help you maintain a regular exercise routine.
Dosing, Frequency, And The Role Of Body Composition
Evidence‑based protocols vary, but several patterns emerge from the clinical and strength‑conditioning literature.
One guidance document for fitness professionals suggests sessions of around ten minutes per area, roughly five times per week, at a distance that delivers low‑level, non‑heating irradiance, often with sessions timed just before or after exercise. Other programs use about fifteen minutes before workouts. In exercise and obesity trials, red or NIR light is typically delivered two or three times per week alongside aerobic or combined training.
The key point is that light is not replacing the calorie deficit or the movement; it is amplifying the metabolic and structural signals those stimuli already generate. Trials where light is used alone, without lifestyle change, consistently show more modest effects.
Your body composition shapes how light distributes. NIRS and Monte Carlo data tell us that thicker subcutaneous adipose layers trap more photons in the fat and reduce sensitivity to deeper muscle. For someone primarily targeting subcutaneous belly fat, that behavior is not necessarily a bug; it means a larger fraction of the incident light is interacting with the fat layer. For someone aiming to recover deep quadriceps or hamstrings, however, a thick adipose layer can be a limiting factor, and adjusting device placement and expectations is important.
A simple real‑world comparison helps. Imagine two people standing in front of the same panel for ten minutes. One has a very thin abdominal fat layer; the other has a thicker one in the range of about 0.4 in. The Monte Carlo and phantom data suggest that the second person’s returning NIR signal at 760 nanometers will be dominated by the fat layer. That person will absorb and scatter a lot of light in fat before any photons reach deeper muscle. That may support fat‑related effects but may require either longer sessions, different angles, or complementary approaches to fully address muscle.
Pros, Cons, And Safety
On the plus side, NIR‑based fat targeting is non‑invasive, generally low risk, and compatible with everyday life. Clinical trials and case series across red/NIR photobiomodulation, low‑level lasers, and infrared saunas report minimal side effects, typically limited to transient redness or mild skin irritation in sensitive individuals. For people who are unwilling or unable to pursue surgical fat reduction, light‑based approaches provide an appealing adjunct.
The pros do come with caveats.
Most of the fat‑loss data are from small, sometimes device‑sponsored studies with carefully controlled protocols and participants who also change diet and exercise. The abdominal girth trial with triple‑wavelength light had only eighteen participants and no control group. The 20‑week trial in obese women and the four‑week LED plus aerobic exercise study are stronger designs but still relatively small. A review from a strength and conditioning organization stresses that red light therapy should be positioned as an adjunct to structured training and nutrition, not as a stand‑alone fat‑loss tool.
There is also the dose and wavelength question. The rat study at 1,100 to 1,800 nanometers demonstrates that high cumulative NIR doses equivalent to a full day of strong sun exposure can non‑thermally remodel adipose tissue and bone marrow over months. That is valuable information if you are designing medical devices; for home users, it is a quiet reminder that “more is better” is not automatically safe or effective.
Finally, measurement and marketing can be misleading. Near‑infrared interactance devices for body composition are easy to use and highly repeatable, but systematic evidence shows that they are not accurate enough to rely on in most populations. If a gadget claims to precisely measure your body fat from a single NIR sensor on the arm, treat that feedback as a rough trend at best, not a gold standard.

A Short FAQ For Light Therapy Geeks
Does “better absorption” in fat automatically mean more fat burning?
Not by itself. Efficient optical interaction means that photons are spending time in the fat layer and some of their energy is being absorbed by lipids, water, and chromophores. For fat burning, you still need a pathway that takes that absorbed energy and turns it into biologically meaningful change: mitochondrial activation, lipolysis, microcirculatory shifts, or adipocyte apoptosis. Human LLLT and exercise‑plus‑light studies show that those pathways can be engaged, but only reliably when you pair light with caloric management and physical activity.
If I have a thick layer of subcutaneous fat, will light therapy work better or worse?
It depends on your goal. For surface and subcutaneous fat, a thicker layer means more interaction volume for the same incident beam. Monte Carlo and phantom work at 760 nanometers clearly demonstrate that increasing fat thickness amplifies the fat contribution to the measured NIR signal. That is a good sign if you are trying to modulate that fat. However, for deeper targets like large muscles, thick fat acts as an optical filter and attenuator. You may need to adjust expectations and possibly make use of multiple angles, longer total exposure, or complementary tools to address deep tissues.
Is it safe to use NIR on my belly every day?
Most low‑level red and NIR protocols used in clinical trials are applied several times per week without serious side effects, and general safety profiles for LED panels and low‑level lasers are excellent when dosed appropriately. At the same time, high‑energy NIR in the 1,100 to 1,800 nanometer range has been shown to cause long‑lasting remodeling in animal fat and bone marrow at doses equivalent to many hours of full sun. The safest approach is to follow device‑specific dosing guidelines, stay within evidence‑based exposure times, avoid treating over active malignancy or unhealed surgical sites, and recognize that daily maximal dosing is not necessary to get benefits.

Closing Thoughts
After years of standing both in front of light panels and behind spectrometers, my view is simple: fat tissue genuinely “likes” near‑infrared light in the sense that it interacts with it strongly, both optically and biologically. The photons that get scattered and absorbed in your subcutaneous fat are not just wasted heat; they are triggers for subtle shifts in adipocyte behavior, microcirculation, and metabolic signaling. If you pair that physics with smart training and nutrition, you can turn an abstract optical window into a very practical tool for reshaping how your fat behaves.
References
- https://epublications.marquette.edu/cgi/viewcontent.cgi?article=1741&context=theses_open
- https://digitalcommons.njit.edu/cgi/viewcontent.cgi?article=1163&context=theses
- https://rave.ohiolink.edu/etdc/view?acc_num=case1057936869
- https://aquila.usm.edu/cgi/viewcontent.cgi?article=21847&context=fac_pubs
- https://en.wikipedia.org/wiki/Near-infrared_window_in_biological_tissue
- https://coilab.caltech.edu/documents/26092/HaiP_2014_Optics_Lett_v39_p5192.pdf
- https://pmc.ncbi.nlm.nih.gov/articles/PMC3052910/
- https://innovation.uci.edu/available-technology/predicting-weight-loss-and-fat-metabolism-using-optical-signal-changes-in-fat/
- https://www.nmr.mgh.harvard.edu/DOT/people/mari/papers/spie99-mari.PDF
- https://opg.optica.org/fulltext.cfm?uri=oe-13-5-1570